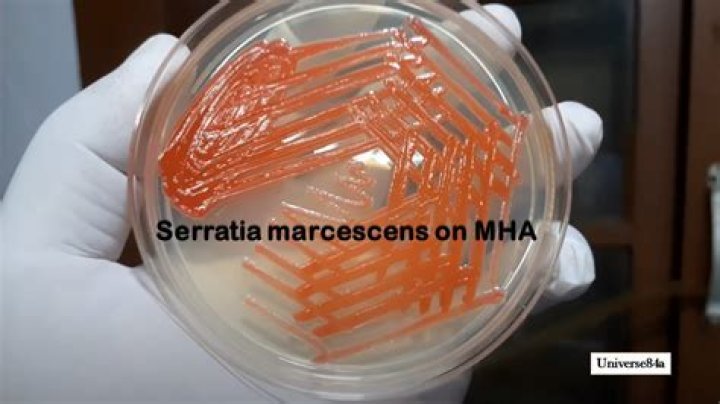
Cover

Does Serratia marcescens grow on EMB?
Eosin methylene blue agar (EMB) is a differential and selective media that supports the growth of gram-negative bacteria, including Escherichia coli and S. marcescens.
Does S aureus grow on EMB?
Non-lactose- fermenting colonies, such as Shigella and Salmonella species, appear transparent and colorless, though some strains of these two genera fail to grow on EMB agar. Occasionally, some Gram-positive bacteria, such as Enterococcus and Staphylococcus will grow on this medium, but usually as pinpoint colonies.
Is S. marcescens Gram-positive or negative?
Serratia marcescens is an opportunistic, gram negative, nosocomial pathogen which belongs to family, Enterobacteriaceae.
What kind of bacteria will grow on an EMB plate?
Some gram-positive bacteria, such as enterococci, staphylococci, and yeast will grow on this medium and usually form pinpoint colonies. Non-pathogenic, non-lactose-fermenting organisms will also grow on this medium.
Does S. marcescens ferment mannitol?
Most pathogenic staphylococci, such as Staphylococcus aureus, will ferment mannitol. Most non-pathogenic staphylococci will not ferment mannitol. The Staphylococcus aureus ferments mannitol and turns the medium yellow. The Serratia marcescens does not grow because of the high salt content.
Does S. marcescens ferment glucose?
Gram staining a sample of the organism from a pure culture revealed that it was a gram negative rod. Mannitol Tubes. Serratia marcescens was able to metabolize mannitol to produce acid, but gas was not produced. Glucose – Positive for the fermentation of glucose to produce acid, but negative for the production of gas.
Does S marcescens grow on MSA?
Organisms from other genera may grow, but they typically grow very weakly. MSA also contains the sugar mannitol and the pH indicator phenol red. The Staphylococcus aureus ferments mannitol and turns the medium yellow. The Serratia marcescens does not grow because of the high salt content.
What carbohydrates are in EMB agar?
Sucrose and lactose serve as fermentable carbohydrate sources which encourage the growth of fecal coliforms and provide a means of differentiating them. Vigorous fermenters of lactose or sucrose will produce quantities of acid sufficient to form the dark purple dye complex.
Is Bacillus subtilis Gram-positive or negative?
Bacillus subtilis is the best-characterized member of the Gram-positive bacteria.
Where are S marcescens?
marcescens) is a gram-negative bacillus that occurs naturally in soil and water and produces a red pigment at room temperature. It is associated with urinary and respiratory infections, endocarditis, osteomyelitis, septicemia, wound infections, eye infections, and meningitis.
What color is E. coli on an EMB plate?
metallic green
Escherichia coli often produces a metallic green sheen on EMB.